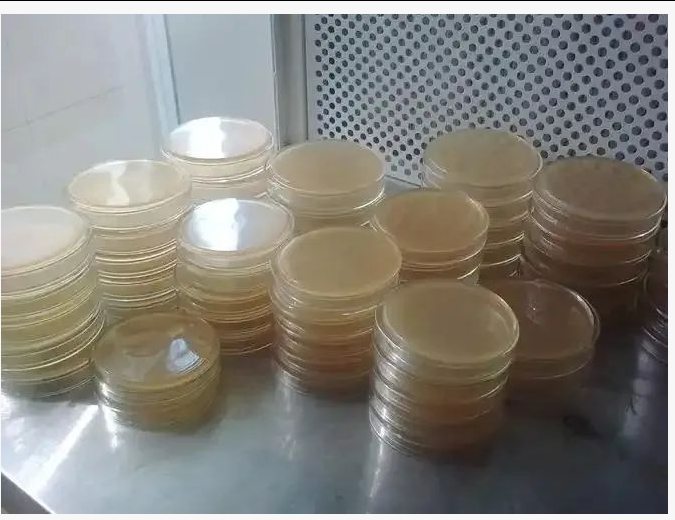

细胞上清液直接测ELISA?小心这个"隐形杀手"(培养基成分干扰)!
点击蓝字
关注我们
ELISA检测暗坑
培养基成分干扰警示
在用细胞上清液直接做ELISA时,你是否被诡异的数据困扰过?其实,培养基成分隐形“背刺”常常是幕后黑手。本文帮你识破干扰、巧妙避坑!
大家好呀!今天咱们聊一个实验室里常见但容易被忽视的坑------用细胞上清液直接测ELISA,结果被培养基成分"背刺"了!
你是不是也遇到过这种情况:辛辛苦苦养了一堆细胞,收了上清,兴冲冲跑去做ELISA,结果数据诡异到让你怀疑人生?别急,可能不是你的实验技术出了问题,而是培养基里的某些成分悄悄干扰了你的检测!
今天,我们就来扒一扒这个"隐形杀手",看看它到底是怎么"搞破坏"的,以及怎么才能优雅地避开它!
01
为什么细胞上清液直接测ELISA可能会翻车?
ELISA(酶联免疫吸附试验)是个好东西,灵敏度高、特异性强,是检测细胞因子、抗体、蛋白表达的常用方法。但问题来了------你的细胞上清液里可不只有目标蛋白,还有一大堆培养基成分!
细胞培养基(比如DMEM、RPMI 1640)里通常含有:血清(如FBS):富含各种蛋白(如牛IgG、生长因子)

酚红:pH指示剂,可能影响吸光度
抗生素、缓冲液、氨基酸等:某些成分可能非特异结合抗体
如果你的ELISA抗体和培养基里的某些成分"撞脸"了,那结果就可能出现:
✅ 假阳性(背景高,信号虚高)
✅ 假阴性(目标蛋白被竞争结合,测不出来)
✅ 数据波动大(重复性差,让人抓狂)
02
培养基里的"干扰分子"到底是谁?
(1)血清蛋白:最大的"戏精"
胎牛血清(FBS)是细胞培养的黄金搭档,但它含有大量牛源蛋白(如IgG、白蛋白)。如果你的ELISA抗体是抗某种细胞因子(比如人IL-6),而它不小心和牛IgG发生了交叉反应......恭喜你,收获一堆假阳性信号!
酚红是培养基里常见的pH指示剂,但它本身有颜色,在450-570 nm(ELISA常用检测波长)可能有吸光值,导致本底升高。
03
如何优雅避开干扰?实验方案优化指南
既然知道了"敌人"是谁,接下来就是见招拆招!
(1)样本前处理:别让干扰物混进去
(2)离心去细胞碎片:上清液收完后,先高速离心(12000 rpm, 10 min),避免细胞碎片干扰
(3)稀释样本:如果信号太强(或背景高),适当稀释样本(用PBS或检测缓冲液)
(4)超滤浓缩(可选):如果目标蛋白浓度太低,可用超滤管浓缩,但注意别把干扰物也浓缩了
(5)选择合适的对照
培养基对照:单独测一次纯培养基,看看本底值
阴性对照:用未刺激的细胞上清,确认基线
标准品溶解液:确保标准品是用类似样本的缓冲液配的,避免基质效应
(6)选对ELISA试剂盒
有些ELISA试剂盒会标明"适用于细胞上清液",这类试剂盒通常优化了抗体,减少交叉反应。如果数据还是不对劲,可以试试不同品牌的试剂盒对比。
睿信ELISA试剂盒
这里要特别推荐一下睿信ELISA试剂盒
✔ 高特异性抗体:减少与血清蛋白的交叉反应
✔ 低背景干扰:优化封闭体系,降低假阳性风险
✔ 即用型标准品:预配在类似样本的基质中,减少稀释误差
✔ 操作简便:省去复杂前处理,直接上样也能获得稳定数据

04
总结:别让培养基毁了你的ELISA!
✅ 细胞上清液直接测ELISA有风险,培养基成分可能是"隐形杀手"!
✅ 主要干扰来源:血清蛋白、酚红、添加剂
✅ 解决方案:优化样本处理、设好对照、选对试剂盒(比如睿信ELISA)
✅ 实在不行?换检测方法!
下次再做ELISA时,记得多留个心眼,别让辛苦养的细胞上清液毁在最后一步!
